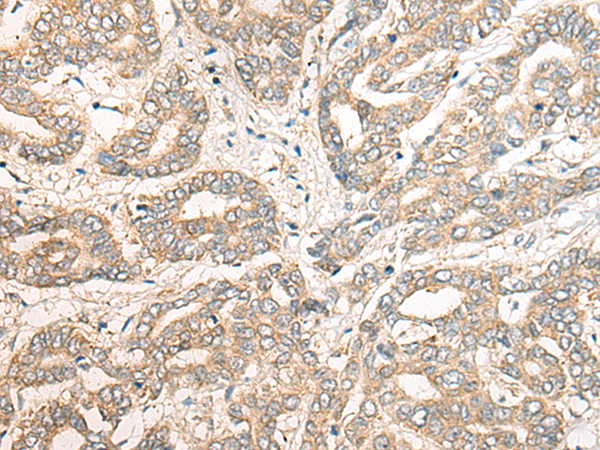

中文名稱 : 兔抗PCDHGB5多克隆抗體
英文名稱 : Anti-PCDHGB5 rabbit polyclonal antibody
別 名 : PCDH-GAMMA-B5
抗 原 : PCDHGB5
儲 存 : 冷凍(-20℃)
宿 主 : Rabbit
反應(yīng)種屬 : Human
相關(guān)類別 : 一抗
標 記 物 : Unconjugate
克隆類型 : rabbit polyclonal
技術(shù)規(guī)格
|
Background: |
This gene is a member of the protocadherin gamma gene cluster, one of three related clusters tandemly linked on chromosome five. These gene clusters have an immunoglobulin-like organization, suggesting that a novel mechanism may be involved in their regulation and expression. The gamma gene cluster includes 22 genes divided into 3 subfamilies. Subfamily A contains 12 genes, subfamily B contains 7 genes and 2 pseudogenes, and the more distantly related subfamily C contains 3 genes. The tandem array of 22 large, variable region exons are followed by a constant region, containing 3 exons shared by all genes in the cluster. Each variable region exon encodes the extracellular region, which includes 6 cadherin ectodomains and a transmembrane region. The constant region exons encode the common cytoplasmic region. These neural cadherin-like cell adhesion proteins most likely play a critical role in the establishment and function of specific cell-cell connections in the brain. Alternative splicing has been described for the gamma cluster genes. |
|
Applications: |
ELISA, IHC |
|
Name of antibody: |
PCDHGB5 |
|
Immunogen: |
Synthetic peptide of human PCDHGB5 |
|
Full name: |
protocadherin gamma subfamily B, 5 |
|
Synonyms: |
PCDH-GAMMA-B5 |
|
SwissProt: |
Q9Y5G0 |
|
ELISA Recommended dilution: |
5000-10000 |
|
IHC positive control: |
Human liver cancer and human brain |
|
IHC Recommend dilution: |
25-100 |
購物車
幫助
021-54845833/15800441009
